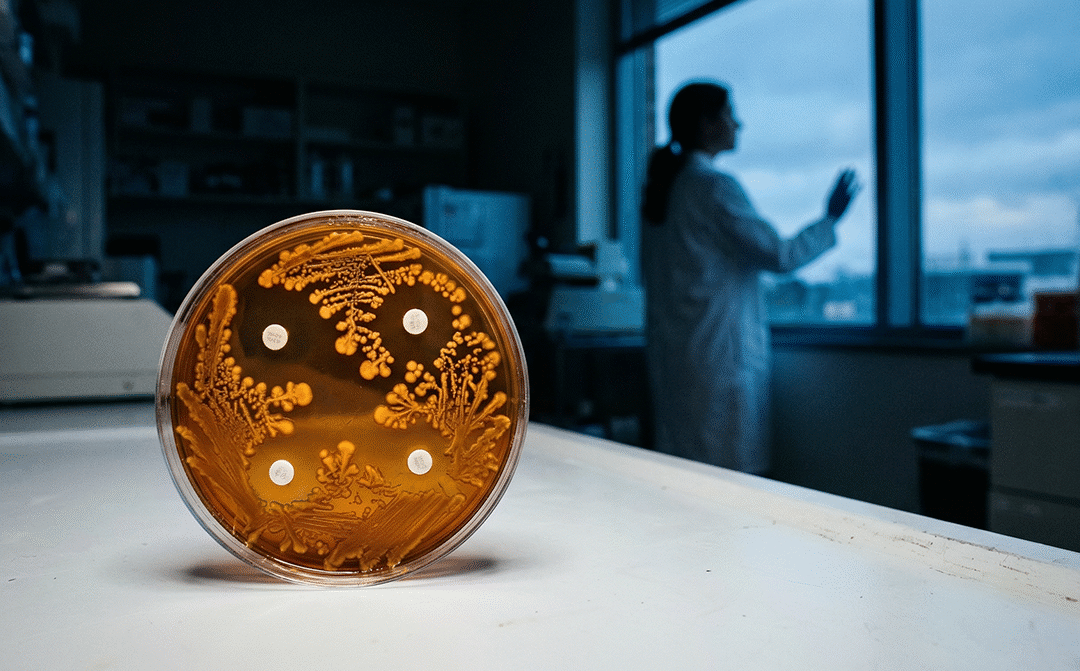
Four Emerging Advances Could Help Humanity Outrun the Antibiotic Resistance Crisis

by John McMillan | Jun 18, 2026 | Health
Guy Guppy, Kingston University Cutting all sugar from your diet sounds like the healthy thing to do. But a recent study suggests it may do more harm than good. Instead of improving metabolic health, it appears to make it worse. Before rewriting your shopping list,...

by John McMillan | Jun 12, 2026 | Health
Andrés Henao, University of Colorado Anschutz When the 2026 FIFA World Cup begins on June 11, 2026, matches will be played across 16 cities in the United States, Canada and Mexico. Millions of fans will arrive through multiple airports and will pack into stadiums,...

by John McMillan | Jun 5, 2026 | Health
Charlie Firth, University of Oxford Tensions have recently emerged around the Ebola response in eastern Democratic Republic of the Congo (DRC). These tensions have manifested in a series of incidents, including the burning of an Ebola treatment facility in Mongbwalu,...

by John McMillan | May 29, 2026 | Health
Helen Pearson, UCL In 1959, a young doctor named David Sackett stumbled on a clinical trial that would change his life – and most of ours. The study showed that conventional wisdom on bed rest in medicine was wrong. And it helped lead Sackett and others to develop...

by John McMillan | Mar 20, 2026 | Health, Medical Research
André O. Hudson, Rochester Institute of Technology Imagine going to the hospital for a bacterial ear infection and hearing your doctor say, “We’re out of options.” It may sound dramatic, but antibiotic resistance is pushing that scenario closer to becoming reality for...

by John McMillan | Mar 6, 2026 | Health
Fiona Newberry, University of Leicester The gut microbiome plays an important role in many aspects of health, from digestion and immune function to metabolic balance and neurological processes. Several diseases have even been associated with changes in the...

Recent Comments